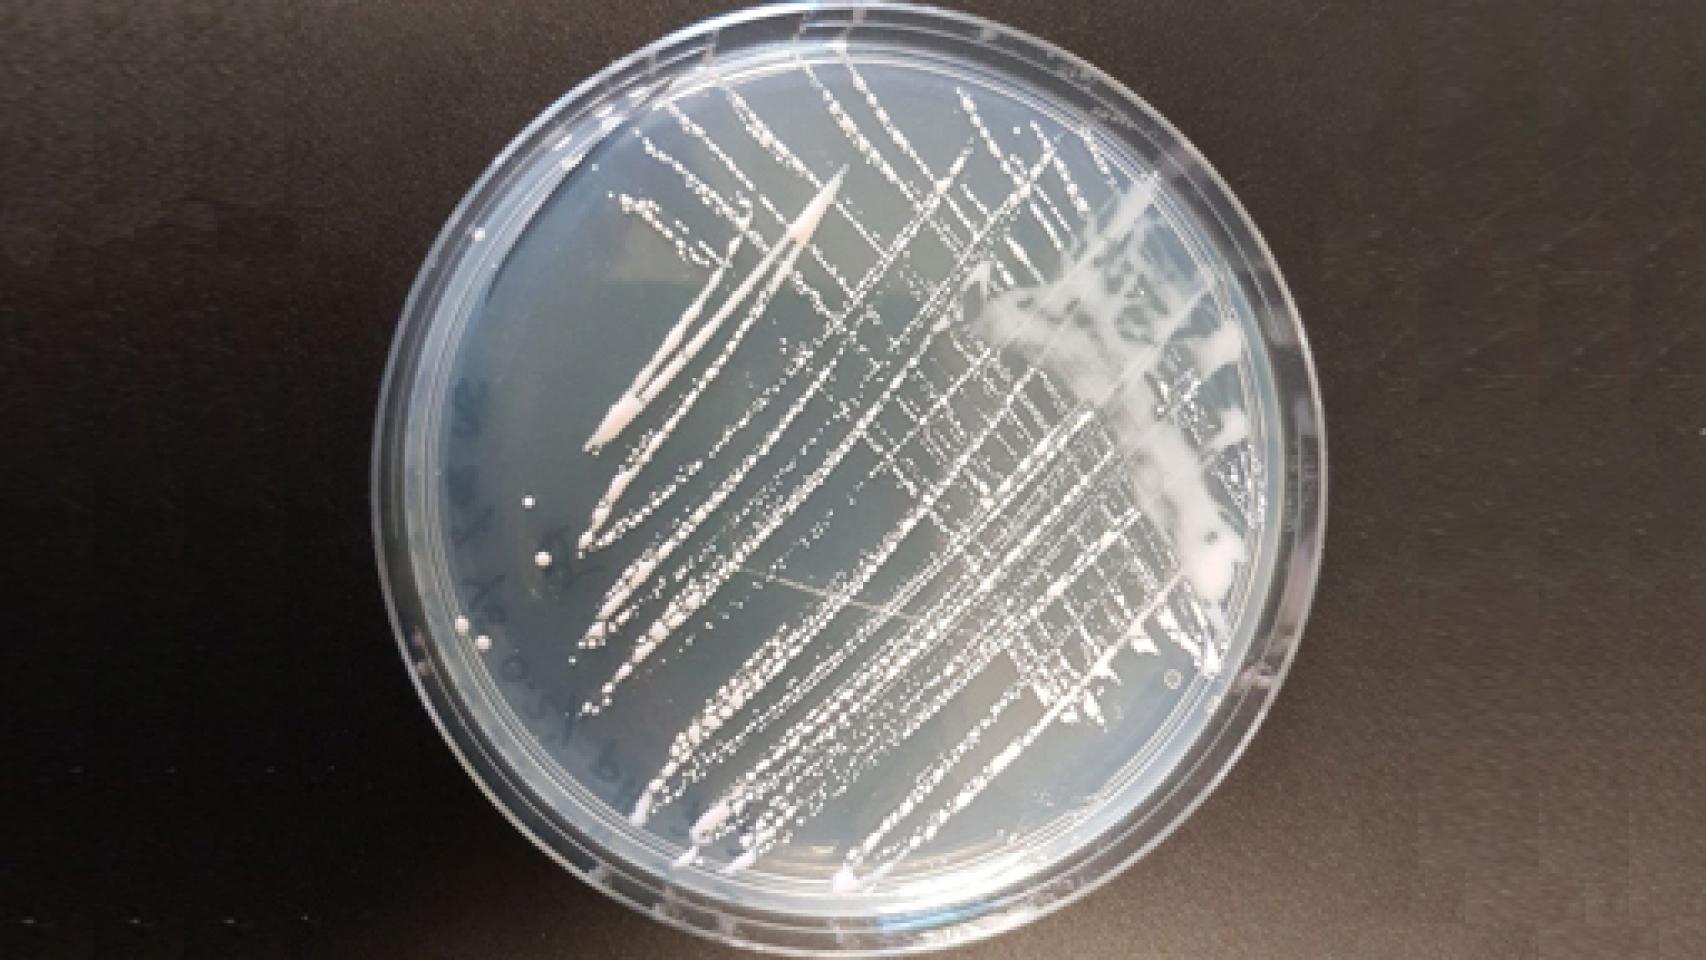
Image: CRISPR, una historia científica intrincada

Cultivo de haloferax mediterranei. Cortesía de Francisco Mojica
El sistema de edición genética denominado CRISPR encabezado y consolidado por los trabajos de Francisco Mojica, Jennifer Doudna y Emmanuelle Charpentier es el motivo del artículo de José Manuel Sánchez Ron. "La actual revolución científica tiene una relación íntima con nuestro cuerpo".
Vivimos desde hace ya décadas inmersos en una revolución científica que afecta al conjunto de las ciencias biomédicas y uno de cuyos epicentros se encuentra en la biología molecular. Las revoluciones que tuvieron lugar en la física durante la primera mitad del siglo XX, asociadas a las teorías de la relatividad y la física cuántica, modificaron radicalmente conceptos tan básicos como los de espacio, tiempo y causalidad, y aportaron novedades como el transistor (1947), un "hijo" de la física cuántica que desencadenó innovaciones que cambiaron, literalmente, nuestro mundo, en las comunicaciones, la economía, el trabajo, las relaciones sociales y un largo etcétera. No es posible, por supuesto, minusvalorar semejante revolución, pero carecía de una característica que la actual revolución biomédica-biológico molecular sí posee: una relación íntima con la vida, en especial con nuestro propio cuerpo y las propiedades y funciones que éste puede desempeñar, entre ellas dos tan importantes como nuestro código genético (genoma) y la reproducción.Las épocas de revoluciones científico-técnicas son tiempos en los que se producen constantemente novedades, innovaciones antes insospechadas. Así, desde que James Watson y Francis Crick propusieran en 1953 su célebre modelo para la molécula de la herencia, el ADN, una doble hélice que se ha convertido en uno de los iconos de nuestro tiempo, no han hecho sino llegar novedades: técnicas para cortar y pegar segmentos de cadenas de ADN (lo que se denomina "ADN recombinante"), con lo que esto significa para diseñar nuevos tipos de vida, animal y vegetal (transgénicos); mapas de genomas; células madre; clonación... A este creciente catálogo de descubrimientos se le ha unido una técnica bautizada con el nombre de CRISPR, acrónimo de "Clustered Regularly Interspaced Palindromic Repeats", esto es, "Repeticiones palindrómicas cortas agrupadas y regularmente interespaciadas" (si no saben lo que significa "palindrómicas", busquen "palíndromo" en el diccionario de la RAE). Se trata de un sistema de "edición genética" -esto es, que, como las técnicas de ADN recombinante, permite modificar un genoma, cortar y pegar, pero con una precisión sin precedentes y con poco coste económico, por lo que esta técnica está transformando profundamente la investigación biológica y médica. Si no han oído hablar antes de CRISPR, no duden de que pronto lo oirán mencionar.
El pasado 31 de enero, la Fundación BBVA concedió uno de los ocho premios Fronteras del Conocimiento, que otorga anualmente, el correspondiente a Biomedicina, a tres científicos cuyas investigaciones han destacado en la creación y desarrollo de CRISPR: la francesa Emmanuelle Charpentier, directora del Instituto Max Planck de Biología de la Infección de Berlín, la estadounidense Jennifer Doudna, catedrática en los Departamentos de Química y de Biología Molecular y Celular de la Universidad de California (Berkeley), y el español Francisco Mojica, profesor titular de Microbiología en la Universidad de Alicante.
En el muy competitivo universo de la investigación científica, con cientos de investigadores y centros que trabajan duramente por llegar el primero a una meta, lo que puede significar no solo gloria académica sino también importantes beneficios económicos, no es raro que sea difícil asignar méritos. El caso de CRISPR es buena prueba de ello. No creo exagerar si digo que existe bastante consenso en reconocer que el inicio de esta revolución se debió a los trabajos que Francisco Mojica emprendió en 1989, para su tesis doctoral en la Universidad de Alicante. No sorprendentemente, escogió estudiar un microbio, Haloferax mediterranei, que había sido aislado en las marismas de Santa Pola y que mostraba una gran tolerancia a la sal.
Al estudiar su genoma, Mojica encontró una estructura muy peculiar, en la que se repetían, nítidamente separadas, ciertas unidades bioquímicas. En 2003, después de haber introducido técnicas bioinformáticas de análisis, se dio cuenta de que en realidad estaba descubriendo unas secuencias repetitivas de ADN que algunas bacterias utilizan como mecanismo de defensa frente a infecciones de virus. Reconociendo la importancia de su hallazgo, Mojica preparó un artículo que envió a la prestigiosa revista Nature, que lo rechazó en noviembre de 2003, con el argumento de que la idea era conocida. En enero de 2004, otra revista, los Proceedings of the National Academy of Sciences de Estados Unidos, decidió que el artículo carecía de suficiente "novedad e importancia" para siquiera someterlo a revisión. Algo parecido sucedió con Molecular Microbiology and Nuclei Acid Research. Finalmente, el Journal of Molecular Evolution lo publicó en 2005, pero tras doce meses de revisiones. Nada nuevo, en realidad, en la historia de la ciencia: un tipo apenas conocido en el mundo científico, de una universidad "menor", que ha hecho un descubrimiento importante.
Como decía antes, la investigación actual es enormemente competitiva y numerosa. Una consecuencia positiva es que se exploran diferentes aspectos de un mismo problema, idea, o técnica. Así, al mismo tiempo que Mojica continuaba con sus trabajos, otros investigadores desarrollaban CRISPR en direcciones diferentes. Es instructivo, en este sentido, leer un artículo publicado en enero de 2016 en una revista de referencia, Cell, "The Heroes of CRISPR", de Eric S. Lander, en el que se asigna el descubrimiento a Mojica. Cito de su conclusión: "La historia de CRISPR es rica en lecciones sobre el ecosistema humano que produce avances científicos que son relevantes para agencias que financian la investigación, el público general e investigadores ambiciosos. La más importante es que los avances más rompedores a menudo surgen de orígenes completamente impredecibles. Los primeros héroes de CRISPR no buscaban una forma de editar el genoma humano, ni siquiera estudiar una enfermedad humana. Sus motivaciones eran una mezcla de curiosidad personal (comprender las extrañas secuencias repetidas en microbios tolerantes a la sal), exigencias militares (defenderse contra la guerra biológica) o aplicaciones industriales (mejorar la producción de yogurt)". Cuando se rapasan los 20 años de historia de CRISPR, encontramos que no han sido pocos los científicos que han intervenido en que se haya convertido en la técnica que ahora es. De hecho, los momentos principales de ese desarrollo tuvieron lugar en laboratorios de, al menos, doce ciudades de nueve países. Sin duda, un logro de especial importancia fue el que llevaron a cabo Doudna y Charpentier, que fue presentado en un artículo (firmado por cuatro autores más) publicado en Science en agosto de 2012. Fue a partir de este trabajo - y de otro, prácticamente simultáneo, del lituano Virginijus Siksnys- cuando la atención sobre CRISPR "se disparó": se ha aplicado, por ejemplo, para intervenir en el genoma de organismos como la levadura, el pez cebra, la mosca de la fruta o monos.
No es sorprendente que Doudna y Charpentier recibieran el Premio Princesa de Asturias de Investigación Científica y Técnica 2015 por, como se dijo al anunciar el galardón, sus trabajos, "que han conducido al desarrollo de una tecnología que permite modificar genes con gran precisión y sencillez en todo tipo de células, posibilitando cambios que suponen una verdadera edición del genoma''. Aun así, lo reconozco, me ha alegrado especialmente saber que la Fundación BBVA ahora también se ha acordado de Mojica. Espero que no sea sólo porque uno es historiador y le preocupa eso de "hacer justicia a la historia".